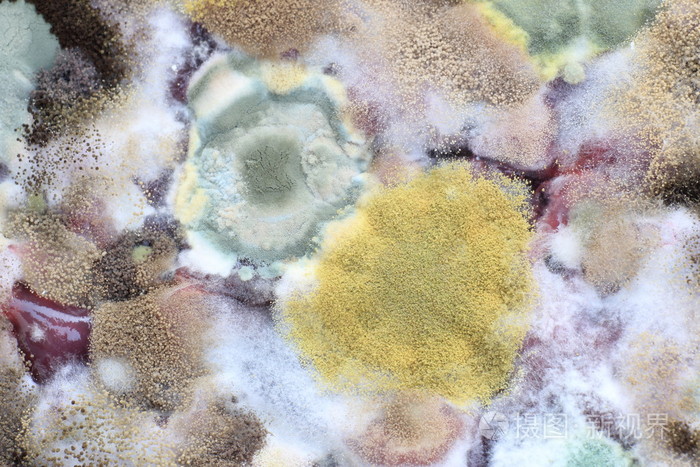
发霉的细菌

霉菌图片

如何控制霉菌污染食品?金华勇洁净车间臭氧杀菌处理!
图片尺寸1080x720
白色背景上分离出的发霉的普通话
图片尺寸681x1023
霉菌其他生物学相关
图片尺寸800x600
在孟加拉红培养基上霉菌和酵母菌的形态是什么样的
图片尺寸2592x1944
发霉图片
图片尺寸525x350
第一次拍霉菌
图片尺寸2048x1536
白色霉菌孢子特写
图片尺寸800x533
霉菌图片
图片尺寸524x350
陕西乾陵博物馆文物长毛,霉菌到底是从哪来的?发霉的原因是啥?
图片尺寸1280x960
发霉的细菌
图片尺寸700x467
梅雨季节,谨防霉菌过敏!
图片尺寸500x337
发霉的细菌
图片尺寸700x467
霉菌图片
图片尺寸300x300
白天,阴影,发霉,朦胧,模糊,反射,影子,食品,面点,食物,糕点,腐烂,霉菌
图片尺寸819x545
霉菌性阴道炎图片
图片尺寸756x500
什么是霉菌
图片尺寸700x350
发霉,老,食物,有毒,许多,彩色_高清图片_全景视觉
图片尺寸522x537
物品防霉有什么作用?_霉菌
图片尺寸1200x800
霉菌
图片尺寸340x339
霉菌mould
图片尺寸1280x853